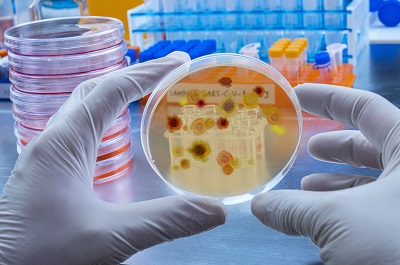
грибки и вирусы

Қара зире майы дегеніміз не? Бұл өнімнің қасиеттері мен қолданылуы
Сіз зире туралы не білесіз? Бұл ашытылған қырыққабаттың дәмін келтіретін ең жақсы дәмдеуіш болып саналады. Алайда, кәдімгі зире өсімдігінің екі кіші түрі бар – қара зире және ақ зире, олар қасиеттері бойынша әр түрлі...